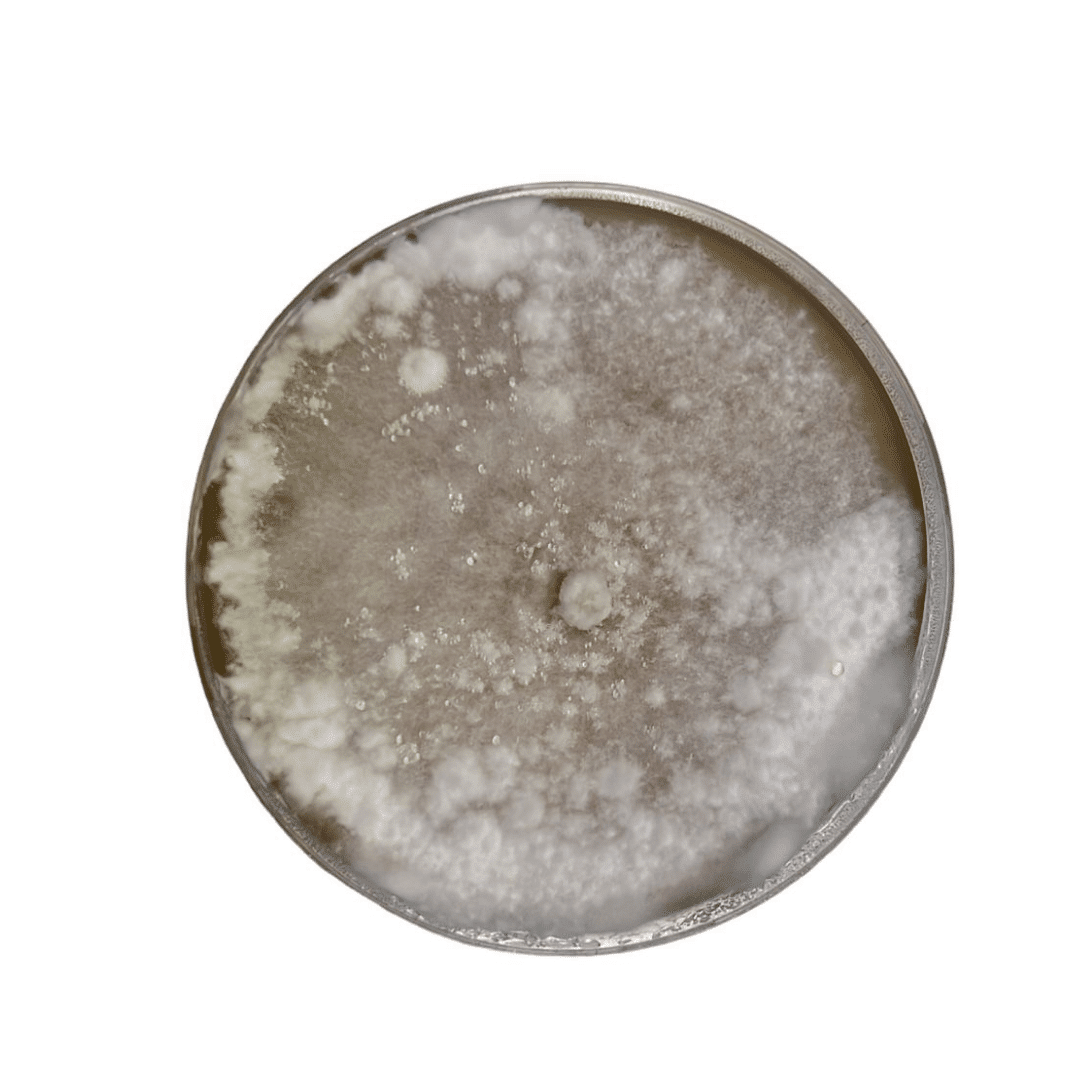
Colonized Mushroom Culture On Agar Plate | Maitake | Grifola frondosa 1 Maitake Colonised mushroom on agar plates after one month

Description
Please watch our video to learn more about P1, P2 and P3 cultures. This video is available in the ‘Video Guide’ tab.
Maitake (Grifola frondosa) Gourmet & Medicinal. Also known as Dancing Hens- Top fruiting, Fruiting temp: 10°-18°C
The colonized mushroom mycelium on agar plates would be sent when they are 60% colonized .
Our agar plates are thick-poured, which helps retain moisture for longer, preventing the plates from drying and making your cultures last longer.
We offer High-Quality Disposable Gloves and Masks, essential for maintaining sterile conditions in your mycology projects.
Agar Plate features
– Fully colonized Live mycelium of your choice on a 90mm Malt Yeast Peptone Agar petri dish.
– Ideal for expansion into grain spawn, liquid cultures, and other Petri dish.
– High in complex food for mycelium to boost mycelium growth.
Your purchase includes
– 1x 90mm Petri dish with inoculum
Did you know that we sell Mushroom culture in form of Liquid culture, Log plug dowel spawn, Agar plate, Mushroom grain spawn, Sawdust Substrate and as Mushroom Growing Kits?